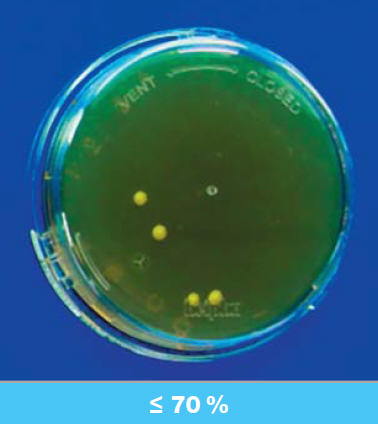

Blog
Schenken Sie Wachstumskontrollen mehr Beachtung
Was sind Wachstumskontrollen?
Die Grundlage für Wachstumskontrollen in der Betriebshygiene sind nicht bewachsene, aerob inkubierte Nährmedien, die bereits für ein Hygienemonitoring benutzt wurden. Dazu zählen etwa Abklatsch- und Sedimentationsplatten.
Falsch negative Ergebnisse können hier auftreten aufgrund von Desinfektionsmittelrückständen auf der Nährmedienoberfläche. Bei Abklatschplattenist dies z. B. durch direkten Kontakt mit der Oberfläche bei der Probenahme, bei Sedimentationsplatten durch das Versprühen des Desinfektionsmittelsbei der Anwendung im umgebenden Raum möglich.
Um die Wachstumsfähigkeit der Nährmediennach der erfolgten Benutzung zu bestätigen, werden diese Nährmedien mit einer definierten Menge einer Keimsuspension beimpft und erneut inkubiert. Die Inkubation nimmt mindestens drei Tage ( bei 22,5 ± 2,5 °C ) plusweitere zwei Tage ( bei 32,5 ± 2,5 °C ), maximal jedoch insgesamt sieben Tagein Anspruch. Um ein möglichst großes Spektrum von Mikroorganismen abdecken zu können, ist es empfehlenswert, aerobe Sporenbildner ( z. B. Bacillus subtilis ), in der Luft vorkommende Keime
( z. B. Kocuria rhizophila, Aspergillus brasiliensis ) sowie Vertreter aus der betrieblichen Hauskeimflora einzusetzen.
Parallel wird für jeden verwendeten Mikroorganismus jeweils eine Inokulum-Kontrolle auf einem entsprechenden Universalmedium angelegt, so z. B. für Bakterien auf Caso-Agar und für Hefenund Schimmelpilze auf Sabouraud-Agar.
Auswertung
Bei der Auswertung der Wachstumskontrollen müssen die untersuchten Medien und die entsprechenden Kontrollenparallel betrachtet werden. Weist das untersuchte Nährmedium üppiges Wachstum auf und liegt die Wiederfindungsrate im Vergleich zur Kontrollebei über 70 Prozent, gilt das Prüfungsergebnis als bestätigt. Eine Wiederfindungsrate unterhalb von 70 Prozentstellt das Prüfungsergebnis zunächst einmal in Frage; als Konsequenz daraus sollte eine Fehleranalyse erfolgen.
Sinn von Wachstumskontrollen
Wachstumskontrollen leisten Hilfestellungbei der Auswertung von unbewachsenenPlatten aus dem Hygienemonitoring.Sie bieten die Sicherheit,ein falsches negatives Ergebnis auszuschließen und gewährleisten damiteine Überprüfung der Funktionalitätdes verwendeten Agars und des darin enthaltenen Enthemmers. Geradein sensiblen Bereichen, in denen die Keimbelastung möglichst gering gehalten werden soll und ein Ergebnis mit KBE = 0 zu erwarten ist, ist es wichtig,die gewonnenen Resultate mit Hilfe von Wachstumskontrollen zu bestätigen. Weiterhin können dadurch Fehlerbei der Probenahme ausgeschlossen werden.
Möglich erscheint beispielsweise, dass das verwendete Nährmedium ungeeignet und der darin enthaltene Enthemmer damit unwirksam für die Anwendungin dem entsprechenden Bereich ist. Wachstumskontrollen dienen auch der Prävention. In diesem Zusammenhang sollte ihnen schon allein aus Gründendes Produktschutzes mehr Beachtung geschenkt werden. Erweist sich z. B. ein Produkt, für das Sterilität vorgeschrieben ist, als unsteril, ist das Suchen und Beseitigen der Sicherheitslücke unter Umständen teurer alsdie routinemäßige Durchführung der Wachstumskontrollen.
Werden keine Wachstumskontrollen durchgeführt, können über einen längeren Zeitraum falsch negative Ergebnisseproduziert werden. Somit würde eine eventuelle Kontaminationsgefahr für das Produkt zunächst unbemerkt bleiben. Bei einer späteren Risikoanalyse müsste ein längerer Zeitraum betrachtetund die Ursachenforschung mit wesentlich mehr Aufwand betrieben werden. Empfehlenswert ist es, die Wachstumskontrollen je nach Umgebungsbedingungen und Anforderung in bestimmten, im Voraus festgelegten Zeitabständen durchzuführen.
Bei der Einführung und bei Änderungeninnerhalb des Reinigungs- und Desinfektionsprozederes oder der verwendeten Medien sind kurzzeitige engmaschigere Kontrollen sinnvoll. Bei erfolgreichen Ergebnissen können die Wachstumskontrollen dann wieder in die übliche Routine integriert werden.
Für Fragen rund um dieses Thema erreichen Sie Ihren Vertriebsansprechpartner
Alexander Pfülb (Telefon +49 9708/9100-525 oder E-Mail alexander.pfuelb@labor-ls.de).
Es freut uns, wenn Sie diesen Blogbeitrag kommentieren. Kommentar erfassen 130 Gefällt mir 584














































































































































